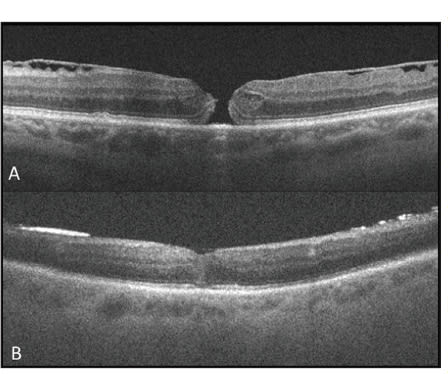

Prospective Assessment Of Intra- and Perioperative OCT For Ophthalmic Surgery: The PIONEER Study
Using OCT during surgery can guide treatment.
JUSTIS P. EHLERS, MD • SUNIL SRIVASTAVA, MD
Optical coherence tomography has revolutionized the clinical care of patients with vitreoretinal disease and transformed diagnostic capability, providing a new barometer for monitoring response to treatment regimens and increased understanding of pathophysiology.
However, while OCT has become the standard of care for monitoring numerous diseases in the clinic, its emergence in the operating room is still in its infancy. Numerous questions remain regarding the use of intraoperative OCT (iOCT) in vitreoretinal diseases, including optimal surgical integration, its impact on anatomic outcomes, and its role in disease-specific management.
The same near-histology detail that has transformed clinical care may have a similar impact on the surgical management of vitreoretinal diseases. Preliminary studies have suggested the utility of iOCT in vitreoretinal surgery.
Some of the information that may be gained from iOCT includes the immediate impact of surgical maneuvers, alterations to intraoperative anatomical configurations, and the influence of OCT on surgical decision-making.
Multiple vitreoretinal surgical diseases have been imaged with iOCT, including macular holes, optic pit– related maculopathy, rhegmatogenous retinal detachments, epiretinal membranes, and retinopathy of prematurity.
| Justis P. Ehlers, MD, and Sunil Srivastava, MD, are assistant professors of ophthalmology at the Cole Eye Institute of the Cleveland Clinic. They both report moderate financial interest in Bioptigen. Dr. Ehlers can be reached via e-mail EHLERSJ@ccf.org. |

Figure 1. Microscope-mounted SD-OCT system (yellow box), which allows for use with a draped or undraped microscope. The entire probe can be draped with the microscope or left undraped (as pictured). Mounting the probe to the microscope allows for rapid and reproducible imaging while minimizing surgical delay.

Figure 2. Intraoperative OCT scans during epiretinal membrane surgery. Preincision scan (A) reveals prominent ERM (red arrow) with inner retinal distortion. Postpeel scan (B) reveals residual membrane (orange arrow) and expansion of the IS/OS and cone outer segment tips to the RPE distance (red arrows). The outer retinal architectural changes are most prominent in the subfoveal area (yellow arrow).
LAUNCHING PIONEER
Identifying the conditions/procedures that benefit from iOCT, correlating structure/function relationships, and optimizing surgical integration must be answered with future research. To address some of these questions, the Cleveland Clinic initiated the PIONEER study.
PIONEER is a prospective, multisurgeon, single-center study examining the use of iOCT and perioperative OCT across ophthalmic surgery. Initiated in late 2011, PIONEER now includes 11 ophthalmic surgeons (six vitreoretinal and five anterior-segment surgeons). In this study, a microscope-mounted portable SD-OCT system is utilized for intraoperative imaging (Figure 1). The mounted system facilitates rapid scan acquisition with excellent reproducibility for intrasurgical comparative analysis, while minimizing surgical disruption.
Optimal scan patterns and acquisition protocols were developed for PIONEER, based on the underlying pathology and surgical procedure being performed. iOCT scanning was performed at various surgeon-specified milestones during a given surgical procedure. A feedback questionnaire was included in the study to assess better the impact of the iOCT on surgical decision-making.

Figure 3. Macular hole segmentation with three-dimensional reconstruction. A volumetric segmentation algorithm allows for quantitative comparison of subtle intraoperative changes in macular hole geometry.3,8
Figure 4. Transtamponade OCT. Preoperative OCT (A) of a full-thickness macular hole with prominent ERM. Transtamponade OCT (B) on postoperative day one showing successful closure with a high-quality grade 4 scan.9
One-year Results
At 12 months, 251 eyes were enrolled in the PIONEER study. Of the 251 eyes, 127 eyes were in the vitreoretinal arm of the study. In 94% of cases, successful imaging could be performed. Most eyes were pseudophakic or had combined phacoemulsification at the time of vitreoretinal surgery. The most common indications for vitreoretinal surgery were ERM, retinal detachment, macular hole, proliferative diabetic retinopathy and vitreomacular traction syndrome.
Images acquired were assessed for microarchitectural alterations, both qualitatively and quantitatively, when applicable. A common intrasurgical architectural change that has emerged is subclinical outer retinal alterations following membrane peeling. This has been noted in ERM, macular hole, and VMT surgery.
Preliminary assessment suggested a significant expansion of the outer retinal hyporeflective band with an increased height in the inner segment/outer segment (ie, ellipsoid layer) to the RPE distance, as well as an increase in the cone outer segment tip (COST, ie, contact cylinder layer) to the RPE height (Figure 2, page 29).
Early analysis examined peeling technique (eg, instrument choice) and surgeon experience as it was correlated to expansion of the subretinal hyporeflectivity band. No correlation was noted with instrument choice or surgeon experience in the preliminary data set.
The functional significance of these changes is unknown. The outer retinal architectural changes associated with membrane peeling appears to be a consistent finding, as our investigators have identified this finding in both ERM and macular hole cases.3,4
Full-thickness architectural changes were also frequently seen at the initiation site of peeling. Functional analysis and postoperative OCT anatomic correlation are currently ongoing. Based on surgeon feedback forms, iOCT appears to identify undetected residual membranes in ~10% of cases that are subsequently peeled based on iOCT findings (Figure 2).
Disease-specific Observations
In macular hole surgery, geometric changes were also noted in the hole configuration following internal limiting membrane peeling with iOCT. Utilizing a novel macular hole segmentation algorithm, volumetric and three-dimensional reconstruction is possible in these macular hole cases (Figure 3).3,4,8
An early analysis subset suggested that following ILM peeling, a significant increase occurs in macular hole volume and base diameter. The impact of these architectural changes on the rate of hole closure is currently under analysis.
In VMT surgery, iOCT was utilized to verify complete release of hyaloid traction and to confirm the integrity of the inner retina. In a small number of cases, iOCT identified subclinical macular hole formation that resulted in changes in surgical management. The changes in management included tamponade choice and ILM peeling.
For macula-involving retinal detachments, eyes in PIONEER underwent vitrectomy (with or without scleral buckle) with perfluorocarbon liquid tamponade and concurrent iOCT imaging. Intrasurgical imaging revealed persistent subretinal fluid under perfluorocarbon liquid in all cases.
Foveal architectural changes were noted, including a select group of cases that appeared to have a subclinical full-thickness macular hole configuration. Preliminary analysis suggested that the foveal configuration under perfluorocarbon liquid that is visualized with iOCT may impact visual outcomes and may suggest a novel mechanism for macular hole configuration.2
Preliminary data from the PIONEER study suggested iOCT can have a significant impact on the surgeon’s understanding of the pertinent surgical pathology and completion of the surgical objectives. Continued analysis of the collected study data continues, particularly examining the structure/function relationships that are vital to understanding the impact of these findings on patient outcomes.
Perioperative Data
PIONEER also includes a perioperative component. On the vitreoretinal side, the focus of the perioperative OCT portion of the study is twofold. First, imaging through a gas tamponade is difficult, and optimizing scan acquisition is vital to being able to identify anatomic configurations in gas-filled eyes
Second, early architectural changes in the perioperative period may help facilitate improved understanding of the healing process and provide important correlations with iOCT findings. To determine rates of macular hole closure better, optimal image quality and localization are needed.
For PIONEER, macular hole patients undergo postoperative imaging at one hour and again at one day. Preliminary results suggest that long scan lengths in pseudophakic eyes appear to have the most success in obtaining a usable image. We previously described a classification system for image quality in transtamponade OCT.9
Utilizing this system, it appears that a grade 3 or 4 image would be required for the accurate determination of hole closure (Figure 4). Additionally, it appears that many architectural changes occur quite rapidly following surgical repair.
Microscope-mounted OCT and More
In the PIONEER study, a microscope-mounted portable SD-OCT probe (Bioptigen) was utilized. Ongoing research in microscope integration will also provide an iterative change that alters the surgical environment for the surgeon and changes the landscape for iOCT.5,10
The current commercially available devices enable intraoperative scanning but require the cessation of surgery prior to performing the scan. This affords the surgeon with an important feedback tool but does not allow for real-time visualization of maneuvers.
Though minimal in the PIONEER study, halting surgery results in increased surgical time, and the add-on OCT system requires additional equipment in the operating room. Other areas of advancement are needed to improve surgical integration.
Instrumentation development is an active area of research that is OCT-friendly. Current instrument materials limit light transmission shadowing the underlying tissues. Additionally, the light scattering properties of metallic instruments are suboptimal, prohibiting the visualization of the instrument itself. Novel surgical instrumentation could optimize OCT visualization of the surgical tool while maximizing resolution of the underlying tissues. Early prototypes are currently under development.
| Intraoperative OCT in Retina |
|---|
|
In addition to the PIONEER study, Duke University launched its own intraoperative OCT study in 2009. This study, in which the National Eye Institute is a collaborator, is testing Duke’s Generation 1 microscope-integrated OCT (MIOCT) operating microscope in several types of ocular surgeries, including macular hole, retinal detachment, diabetic vitrectomy, rare macular diseases, and vitreoretinal interface disorders. Two anterior-segment study groups are also being enrolled. By the time the study is completed, in January 2018, the investigators intend to enroll more than 800 subjects, with 500 enrolled in the retina arms. While testing the G1 MIOCT, the Duke team, like the PIONEER investigators at Cole, is also using Bioptigen’s handheld SD-OCT device. Two research articles appeared earlier this year by the Duke study team: one was published in the January issue of Graefe’s Archive of Clinical and Experimental Ophthalmology, and the other appeared online in March, published in Retina. While the Duke study is currently only enrolling in North Carolina, enrollment at Cole is expected to begin in the near future. Drs. Ehlers and Srivastava, the authors of this feature on PIONEER, will collaborate on that part of the NEI-sponsored trial. Full details of the Duke intraoperative OCT trial can be found online at http://clinicaltrials.gov/ct2/show/NCT01588041. —Andrew E. Mathis, PhD, Medical Editor |
Dynamic imaging will also be critical for real-time imaging. Novel scan protocols with specialized image processing have been described that allow for OCT-based capture of intraocular surgical motion of surgical maneuvers.11
An important aspect of optimal visualization of surgical manipulation will be the efficient targeting of the OCT beam to the area of interest. Software packages for rapid computational analysis of architectural changes are being developed to enhance surgical feedback and surgeon information.
Finally, a safe and efficient surgeon feedback environment will be needed. Heads-up display or alternative display systems will need to be considered to provide optimal imaging feedback while maintaining surgical feedback.
CONCLUSION
The overall clinical impact of iOCT is still unknown. The early data from the PIONEER study has suggested iOCT may have an important role in surgical feedback and facilitating surgical decision-making. Continued research in this area will hopefully provide a framework for vitreoretinal surgeons to integrate iOCT into their surgical practices.
As we learn more about this technology and how to optimize surgical care, iOCT may become one of the next paradigm shifts in ophthalmic surgery. RP
REFERENCES
1. Ehlers JP, Kernstine K, Farsiu S, Sarin N, Maldonado R, Toth CA. Analysis of pars plana vitrectomy for optic pit-related maculopathy with intraoperative optical coherence tomography: a possible connection with the vitreous cavity. Arch Ophthalmol. 2011;129:1483-1486.
2. Ehlers JP, Ohr MP, Kaiser PK, Srivastava SK. Novel microarchitectural dynamics in rhegmatogenous retinal detachments identified with intraoperative optical coherence tomography. Retina. 2013; in press.
3. Ehlers JP, Xu D, Kaiser PK, Singh RP, Srivastava SK. Intrasurgical dynamics of macular hole surgery: an assessment of surgery-induced ultrastructural alterations with intraoperative optical coherence tomography. Retina. 2013; in press.
4. Ray R, Baranano DE, Fortun JA, et al. Intraoperative microscope-mounted spectral domain optical coherence tomography for evaluation of retinal anatomy during macular surgery. Ophthalmology. 2011;118:2212-2217.
5. Binder S, Falkner-Radler CI, Hauger C, Matz H, Glittenberg C. Feasibility of intrasurgical spectral-domain optical coherence tomography. Retina. 2011;31:1332-1336.
6. Chavala SH, Farsiu S, Maldonado R, Wallace DK, Freedman SF, Toth CA. Insights into advanced retinopathy of prematurity using handheld spectral domain optical coherence tomography imaging. Ophthalmology. 2009;116:2448-2456.
7. Dayani PN, Maldonado R, Farsiu S, Toth CA. Intraoperative use of handheld spectral domain optical coherence tomography imaging in macular surgery. Retina. 2009;29:1457-1468.
8. Xu D, Yuan A, Kaiser PK, et al. A novel segmentation algorithm for volumetric analysis of macular hole boundaries identified with optical coherence tomography. Invest Ophthalmol Vis Sci. 2013;54:163-169.
9. Ehlers JP, Yuan A, Kaiser PK, et al. Trans-tamponade optical coherence tomography: postoperative imaging in gas-filled eyes. Retina. 2013; in press.
10. Ehlers JP, Tao YK, Farsiu S, Maldonado R, Izatt JA, Toth CA. Integration of a spectral domain optical coherence tomography system into a surgical microscope for intraoperative imaging. Invest Ophthalmol Vis Sci. 2011;52:3153-159
11. Ehlers JP, Tao YK, Farsiu S, Maldonado R, Izatt JA, Toth CA. Visualization of real-time intraoperative maneuvers with a microscope mounted spectral domain optical coherence tomography system. Retina. 2012; in press.








